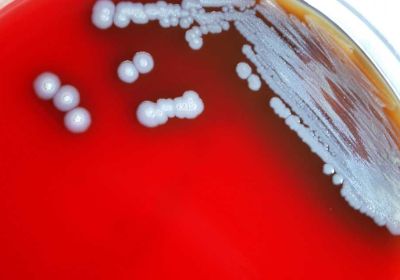

भोपाल

स्वास्थ्य शिविरों का लाभ लें राज्यपाल ने किया आव्हान
23 Sep, 2025 09:15 PM IST | ASIAVARTANEWS.COMभोपाल राज्यपाल श्री मंगुभाई पटेल धरती आबा जनजातीय ग्राम उत्कर्ष अभियान के अंतर्गत आदि साथी एवं...

सतपुड़ा ताप विद्युत गृह, सारणी की 11 हजार 678 करोड़ 74 लाख रुपये की पुनरीक्षित लागत का अनुमोदन
23 Sep, 2025 08:33 PM IST | ASIAVARTANEWS.COM13 स्वशासी चिकित्सा महाविद्यालयों में सीनियर रेसीडेंट के 354 नवीन पदों के सृजन की स्वीकृति मुख्यमंत्री...

डाक कर्मचारी विनोद गोडबोले और आईटी प्रोफेशनल धर्मेंद्र-जोगी, आदर्श सक्सेना ने जीतकर रचा नया इतिहास
23 Sep, 2025 07:51 PM IST | ASIAVARTANEWS.COMभोपाल मैराथन वैसे ही बहुत कठिन स्पर्धा होती है। उस पर औसतन चार हजार मीटर की...

सिंहस्थ 2028 की तैयारियां तेज़, मंत्री विजयवर्गीय ने अधिकारियों को दिए नियमित निरीक्षण के निर्देश
23 Sep, 2025 07:22 PM IST | ASIAVARTANEWS.COMविजयवर्गीय का निर्देश: सिंहस्थ की तैयारियों में लापरवाही नहीं, अधिकारी करें नियमित निरीक्षण गुणवत्ता के साथ...

स्कूल और निजी बसों के लिए नए नियम लागू, मध्य प्रदेश में Motor Vehicle Act 2025 को मिली मंजूरी
23 Sep, 2025 05:49 PM IST | ASIAVARTANEWS.COMभोपाल मध्य प्रदेश में बिना परमिट बस दौड़ाने पर वाहन मालिकों को भारी नुक्सान उठाना पड़...

राज्यमंत्री श्रीमती गौर ने सफाई और प्रकाश की समुचित व्यवस्था सुनिश्चित करने के भी दिए निर्देश
23 Sep, 2025 05:23 PM IST | ASIAVARTANEWS.COMभोपाल पिछड़ा वर्ग एवं अल्पसंख्यक कल्याण राज्यमंत्री (स्वतंत्र प्रभार) श्रीमती कृष्णा गौर ने कहा कि मां...

देशभर में 9 करोड़ से अधिक मरीजों को आयुष्मान भारत योजना ने दी मुफ्त स्वास्थ्य सेवा
23 Sep, 2025 05:22 PM IST | ASIAVARTANEWS.COMभोपाल आयुष्मान भारत योजना को लागू हुए 7 साल पूरे हो गए हैं। 12 सितंबर 2018...

सतपुड़ा ताप विद्युत गृह, सारणी की 11 हजार 678 करोड़ 74 लाख रुपये की पुनरीक्षित लागत का अनुमोदन
23 Sep, 2025 04:23 PM IST | ASIAVARTANEWS.COMमंत्रि-परिषद ने सार्वजनिक निजी भागीदारी से हैलीकॉप्टर सेवा संचालन की दी स्वीकृति सतपुड़ा ताप विद्युत गृह,...

मध्य प्रदेश से जल्द विदा लेगा मानसून, 25-26 को झमाझम बारिश का अनुमान, आज कुछ जिलों में फुहारें
23 Sep, 2025 04:18 PM IST | ASIAVARTANEWS.COMभोपाल मध्यप्रदेश में इन दिनों मौसम का मिजाज बार-बार रंगत बदल रहा है। कहीं गरज चमक...

मुख्यमंत्री डॉ. यादव ने भगवान धन्वंतरि की प्रतिमा पर किया माल्यार्पण
23 Sep, 2025 04:17 PM IST | ASIAVARTANEWS.COMभोपाल राष्ट्रीय आयुर्वेद दिवस मुख्यमंत्री डॉ. मोहन यादव ने राष्ट्रीय आयुर्वेद दिवस पर मुख्यमंत्री निवास में आरोग्य...

राजधानी भोपाल में गरबा पर सख्ती! एंट्री के लिए अनिवार्य होगी पहचान, ये हैं नए दिशा-निर्देश
23 Sep, 2025 03:22 PM IST | ASIAVARTANEWS.COMभोपाल भोपाल में इस नवरात्रि के मौके पर गरबा और डांडिया को लेकर प्रशासन ने सख्त...
मेलियोइडोसिस का खतरा बढ़ा! मध्यप्रदेश समेत 4 राज्यों में अलर्ट, गलत इलाज बना जानलेवा
23 Sep, 2025 02:22 PM IST | ASIAVARTANEWS.COMभोपाल मध्य प्रदेश में नई बीमारी की दस्तक से स्वास्थ्य विभाग में हड़कंप मचा हुआ है....

10वां राष्ट्रीय आयुर्वेद दिवस: सीएम आज दोपहर 3 बजे करेंगे राज्य स्तरीय कार्यक्रम का उद्घाटन
23 Sep, 2025 01:23 PM IST | ASIAVARTANEWS.COMभोपाल मुख्यमंत्री आयुष जनस्वास्थ्य कार्यक्रम का 55 जिले की 55 इकाई में प्रसार एवं कैंसर रोगियों...

हम सब मिलकर बनायेंगे आत्मनिर्भर और विकसित भारत: मुख्यमंत्री डॉ. यादव
23 Sep, 2025 01:20 PM IST | ASIAVARTANEWS.COMघटी जीएसटी, मिला बचत का मीठा उपहार : मुख्यमंत्री डॉ. यादव हम सब मिलकर बनायेंगे आत्मनिर्भर...

सामाजिक एकता का संदेश: मंत्री नरेंद्र शिवाजी पटेल ने दलित परिवार के घर खाया खाना
23 Sep, 2025 12:38 PM IST | ASIAVARTANEWS.COMरायसेन रायसेन में जिस दलित परिवार के यहां भोजन करने वालों का सामाजिक बहिष्कार हुआ था,...


 1 नवम्बर 2025 राशिफल: मकर राशि वालों को मिलेगा भाग्य का साथ, बाकी राशियों पर कैसा रहेगा असर
1 नवम्बर 2025 राशिफल: मकर राशि वालों को मिलेगा भाग्य का साथ, बाकी राशियों पर कैसा रहेगा असर पाकिस्तान के बलूचिस्तान में इंटरनेट ठप, सरकार ने 24 घंटे के ब्लैकआउट का दिया आदेश
पाकिस्तान के बलूचिस्तान में इंटरनेट ठप, सरकार ने 24 घंटे के ब्लैकआउट का दिया आदेश शी जिनपिंग और दक्षिण कोरियाई राष्ट्रपति आमने-सामने, वैश्विक अर्थव्यवस्था पर हुई बड़ी चर्चा
शी जिनपिंग और दक्षिण कोरियाई राष्ट्रपति आमने-सामने, वैश्विक अर्थव्यवस्था पर हुई बड़ी चर्चा खुफिया रिपोर्ट में बड़ा खुलासा: पाकिस्तान तैयार कर रहा ISIS के 1,000 आतंकी, जम्मू-कश्मीर पर नजर
खुफिया रिपोर्ट में बड़ा खुलासा: पाकिस्तान तैयार कर रहा ISIS के 1,000 आतंकी, जम्मू-कश्मीर पर नजर राजनाथ सिंह का सख्त रुख: भारत दक्षिण चीन सागर में स्वतंत्र नौवहन और कानून आधारित व्यवस्था का समर्थक
राजनाथ सिंह का सख्त रुख: भारत दक्षिण चीन सागर में स्वतंत्र नौवहन और कानून आधारित व्यवस्था का समर्थक PM मोदी का सम्मान भाषण: आर्य समाज ने भारत को एकता और स्वाभिमान का मार्ग दिखाया
PM मोदी का सम्मान भाषण: आर्य समाज ने भारत को एकता और स्वाभिमान का मार्ग दिखाया देशभर में फैला साइबर ठगी नेटवर्क ध्वस्त, बैंक अफसर भी निकला गिरोह का हिस्सा!
देशभर में फैला साइबर ठगी नेटवर्क ध्वस्त, बैंक अफसर भी निकला गिरोह का हिस्सा! सुरक्षा के मद्देनज़र सिवनी हवाला कांड के 10 पुलिसकर्मी आरोपियों को केंद्रीय जेल नरसिंहपुर भेजा गया
सुरक्षा के मद्देनज़र सिवनी हवाला कांड के 10 पुलिसकर्मी आरोपियों को केंद्रीय जेल नरसिंहपुर भेजा गया चुनाव से पहले बड़ा झटका: यूनुस की रणनीति फेल, विरोध की लहर तेज़
चुनाव से पहले बड़ा झटका: यूनुस की रणनीति फेल, विरोध की लहर तेज़ रोहित आर्य का अजीबो-गरीब ड्रामा: पटाखों की आवाज़ पर बोला ‘फायरिंग चल रही है’!
रोहित आर्य का अजीबो-गरीब ड्रामा: पटाखों की आवाज़ पर बोला ‘फायरिंग चल रही है’!